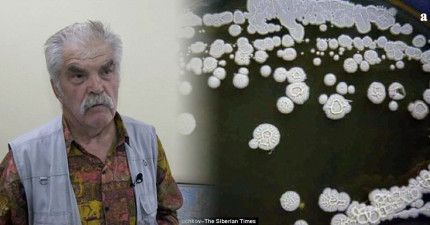

準備移民火星編寫的文章


18位「在2015年片酬最高的好萊塢女星」,沒想到這些熟面孔拍片居然是領這種天文數字…

科學家揭露「光看你的身高和體重」就能知道你曾經有過或會有幾個愛愛對象!
October 2, 2015
將「活了3500萬年的細菌」冒死注入自己體內後,這名科學家說他可能找到讓人類永生的關鍵了!
October 2, 2015

你從小最喜歡的「X嘴米飛兔」真實身分其實是一秒會把你給吞了的恐怖異型?!

聽完這位「全球最窮總統」的一席話,我發現我的人生出現了好的轉機!
October 2, 2015

在你Facebook個人資料裡可能暗藏了讓你超害羞的資料,而且大家都看得到!

這個男子在飛機上被毒蛛咬傷,終於下飛機時他的傷口真的已經「炸開了」!
October 1, 2015

保羅沃克的女兒控告保時捷害死爸爸,結果保時捷的殘酷答覆摧毀了她!

在一陣狂風把教宗領子吹起來後,網友們又開始突破極限爆笑改圖了!
October 1, 2015

看到這些「不承認中共政權」的國家後,我才知道台灣外交沒有我想像中的那麼弱勢!
September 30, 2015

他們的6歲兒子因為玩沙而喪命後,父母在桌上找到兒子「讓人溫暖又心碎的最後留言」。
September 30, 2015